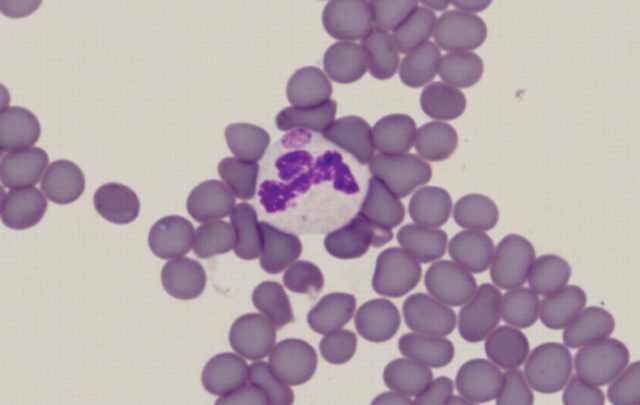

Contenido
La anaplasmosis del ganado (ganado) es una enfermedad parasitaria bastante común que puede causar un daño significativo a la salud animal. La enfermedad rara vez conduce a la muerte del ganado, sin embargo, es difícil y su tratamiento está asociado con considerables inversiones financieras y costos de tiempo. Es por ello que la lucha contra esta enfermedad se combina con un conjunto de medidas preventivas destinadas a prevenir la reinfección. El peligro de la enfermedad radica en el hecho de que incluso después de la recuperación, algunos de los animales recuperados continúan portando la infección.
Que es la anaplasmosis
La anaplasmosis bovina es una peligrosa infección sanguínea parasitaria que provoca calambres en las extremidades, fiebre, agotamiento físico severo de los animales, anemia y el desarrollo de patologías irreversibles en el trabajo de los órganos internos del ganado. Dichos procesos están asociados con la actividad vital de las bacterias unicelulares (anaplasma), que se multiplican rápidamente en la sangre de un individuo enfermo y llenan los vasos sanguíneos en el menor tiempo posible. En riesgo de anaplasmosis bovina son principalmente las vacas, cabras y ovejas.
Las bacterias dañinas viven colonialmente y en una alta concentración de anaplasma en la sangre, el metabolismo en el cuerpo del animal se interrumpe y los procesos redox se suspenden. En última instancia, cortan el suministro de oxígeno a los órganos internos y tejidos del ganado, lo que conduce a la falta de oxígeno. Cuando se descuida la enfermedad, se diagnostica anemia en el ganado.
Ciclo de vida del anaplasma
Los anaplasmas son parásitos con dos huéspedes. Se alimentan de los nutrientes que se encuentran en la sangre del ganado, pero pasan de un individuo a otro principalmente en el cuerpo de las garrapatas y otros insectos. Cuando un vector de enfermedad se adhiere a un animal, los microorganismos dañinos ingresan al torrente sanguíneo del ganado. Poco después de la infección del ganado, los anaplasmas comienzan a multiplicarse rápidamente dentro de los eritrocitos, plaquetas y leucocitos, formando colonias completas en cuestión de días. La reproducción ocurre por gemación o división de la célula madre.
Las bacterias ingresan al cuerpo de las garrapatas u otros vectores de la anaplasmosis al chupar la sangre de los animales infectados. En el cuerpo de los insectos, los parásitos se multiplican principalmente en los intestinos y los vasos de Malpighi, desde donde pueden transmitirse a la descendencia de los portadores de la infección.
Por lo tanto, el ciclo de vida del anaplasma incluye las etapas de reproducción tanto en el cuerpo de los insectos, los principales portadores de la anaplasmosis, como en el cuerpo del ganado.
Condiciones para la propagación de la enfermedad.
Las principales fuentes de anaplasmosis son los insectos chupadores de sangre, que incluyen:
- garrapatas ixodid;
- mosquitos
- tábanos
- picadores de escarabajos;
- moscas;
- chupasangres de ovejas;
- mosquitos.
No es raro que un brote de anaplasmosis sea el resultado del contacto del ganado con herramientas o equipos infectados.
Síntomas de anaplasmosis en ganado.
La efectividad del tratamiento depende en gran medida de la etapa en la que se diagnosticó la anaplasmosis en el ganado. Para hacer esto, necesita conocer los primeros signos de infección con una infección:
- un fuerte aumento de la temperatura corporal del animal;
- decoloración de las membranas mucosas del ganado: un exceso de bilirrubina en la sangre de las personas enfermas conduce al hecho de que las membranas mucosas adquieren un tinte amarillento;
- respiración pesada e intermitente causada por la falta de oxígeno;
- pulso rápido;
- agotamiento físico, el ganado está perdiendo peso rápidamente;
- falta de apetito;
- letargo, apatía de comportamiento;
- tos;
- alteración del tracto digestivo;
- disminución de la producción de leche;
- hinchazón de las extremidades y papada en las últimas etapas de la anaplasmosis;
- esterilidad en machos;
- abortos espontáneos en embarazadas;
- debilidad;
- convulsiones y fiebre;
- anemia.
El curso de la enfermedad
Los anaplasmas que han penetrado en la sangre del ganado provocan trastornos metabólicos en el cuerpo del animal e inhiben los procesos redox. Como resultado, se reduce la vida útil de los eritrocitos y se altera la hematopoyesis. La hemoglobina en la sangre cae y esto, a su vez, provoca falta de oxígeno.
El suministro insuficiente de oxígeno a los tejidos y órganos del ganado durante la anaplasmosis provoca anemia y hemoglobinuria. Como resultado de la interrupción de los procesos metabólicos en el ganado, comienza una rápida acumulación de toxinas en el cuerpo de las personas infectadas. La intoxicación provoca el desarrollo de procesos inflamatorios, hinchazón y posterior hemorragia en los órganos internos del ganado.
Diagnósticos
El tratamiento de la enfermedad se complica por el hecho de que no es tan fácil diagnosticar la anaplasmosis. Sus síntomas se superponen en gran medida con una serie de otras enfermedades, lo que conduce a diagnósticos erróneos y a la elección del régimen de tratamiento incorrecto.
Muy a menudo, la anaplasmosis del ganado se confunde con las siguientes enfermedades:
- babesiosis;
- ántrax;
- leptospirosis;
- piroplasmosis;
- teileriosis.
El diagnóstico correcto solo es posible después de estudios de laboratorio de un frotis de sangre de un individuo con sospecha de anaplasmosis.
Tratamiento de la anaplasmosis en bovinos
Ante los primeros signos de enfermedad, el individuo infectado se separa del rebaño para confirmar el diagnóstico y el tratamiento posterior.
En la lucha contra la anaplasmosis, se usa todo un complejo de medicamentos. En particular, los siguientes medicamentos han funcionado bien:
- "Morfociclina";
- "Terramicina";
- "Tetraciclina".
Estos medicamentos se administran por vía intramuscular a animales enfermos después de diluirlos en una solución de novocaína (2%). Dosis: 5-10 mil unidades por 1 kg de peso vivo. El curso del tratamiento dura de 5 a 6 días, el medicamento se administra a diario.
No menos popular es la "oxitetraciclina 200", un fármaco que tiene un efecto a largo plazo en el cuerpo del animal. También se administra por vía intramuscular, una vez al día a intervalos de 4 días.
La recuperación rápida se ve facilitada por el tratamiento con "Brovaseptol", que se administra a una persona enferma una vez al día a intervalos de 1 día. Dosis: 0,1 ml por 1 kg de peso vivo.
Otro método consiste en el tratamiento del ganado bovino con "Sulfapiridazina", que previamente se diluye en agua, en una proporción de 1:10. La dosis recomendada del medicamento de acuerdo con las instrucciones: 0.05 g por 1 kg de peso vivo.
La solución alcohólica de "lactato de etacridina", que se prepara mezclando el fármaco con alcohol etílico, destruye eficazmente el anaplasma. Proporciones: 0,2 ml de la droga, 60 ml de alcohol y 120 ml de agua destilada. La mezcla resultante se agita y filtra a fondo, después de lo cual se inyecta en el cuerpo de un individuo enfermo por vía intravenosa.
Independientemente del fármaco elegido para el tratamiento de la anaplasmosis, es necesario proporcionar al ganado una nutrición adecuada. En los animales enfermos, los procesos metabólicos se alteran, por lo tanto, se deben agregar alimentos fácilmente digeribles a la dieta de los animales.También es importante que el ganado siempre tenga libre acceso a agua potable fresca. Se agregan suplementos vitamínicos al alimento.
Sustentabilidad
El ganado que ha tenido anaplasmosis gana inmunidad a la infección, sin embargo, la resistencia no dura mucho. La inmunidad desaparece en promedio 4 meses después de la recuperación. Si una persona embarazada está enferma, su descendencia puede recibir una inmunidad más prolongada a la enfermedad debido a la ingesta de anticuerpos en el cuerpo. En caso de infección, la anaplasmosis en los cachorros será más leve.
Pronóstico
El pronóstico de la anaplasmosis es generalmente favorable. Si la enfermedad se diagnostica a tiempo y el tratamiento se aborda de forma integral, se puede evitar la muerte. La falta de un tratamiento adecuado agota gravemente el cuerpo de los animales. La auto-recuperación es casi imposible debido a cambios irreversibles en el trabajo de los órganos del ganado, que son causados por la actividad vital del anaplasma.
Medidas preventivas
La prevención de la anaplasmosis incluye un conjunto de las siguientes medidas:
- Si se ha producido un brote de la enfermedad en el área, los animales de la región con el foco de la infección se tratan con repelentes de insectos especiales que transmiten anaplasmosis. Las garrapatas son la principal amenaza para el ganado.
- Los pastos para el pastoreo de ganado también deben descontaminarse. Si esto no es posible, se intensifica la desinfección del ganado: el procesamiento del pelo de los animales se lleva a cabo todas las semanas.
- El contacto de nuevos individuos con la manada se permite solo después de la cuarentena, que debe durar al menos 1 mes. Durante este tiempo, se examina al animal en busca de síntomas de anaplasmosis. Si no se notaron signos de la enfermedad, se envía al recién llegado a sus familiares.
- Al menos 3 veces al año, se recomienda realizar un procedimiento de desacarización de los locales donde se ubica el ganado, patios, así como herramientas y equipos adicionales utilizados para la alimentación y contacto con los animales.
- Después de un brote de anaplasmosis en el área de la cría de ganado, es recomendable asegurarse de que la dieta de los animales en los meses de invierno incluya suplementos de vitaminas y minerales.
- Para prevenir la infección masiva del ganado con anaplasmosis, los animales deben ser vacunados. La vacunación tiene una duración de 1 año, aumentando la resistencia del ganado a la infección.
Conclusión
La anaplasmosis del ganado prácticamente no se acompaña de la muerte masiva de animales en la actualidad, pero la lucha contra esta enfermedad es muy agotadora y la recuperación no garantiza en absoluto que no se produzca pronto un segundo brote de anaplasmosis. Incluso después de un curso de tratamiento, el ganado a menudo sigue siendo portador de la infección y la transfiere a personas sanas. Además, la inmunidad desarrollada después de la infección es de corta duración y desaparece después de unos meses. Por eso es tan importante cumplir con todas las medidas preventivas diseñadas para prevenir la propagación de la anaplasmosis entre los animales. Al mismo tiempo, la mejor forma de prevenir la infección es vacunar al ganado con anticipación.
Puede encontrar más información sobre el tratamiento de parásitos, infecciones transmitidas por garrapatas y anaplasmosis en el siguiente video: